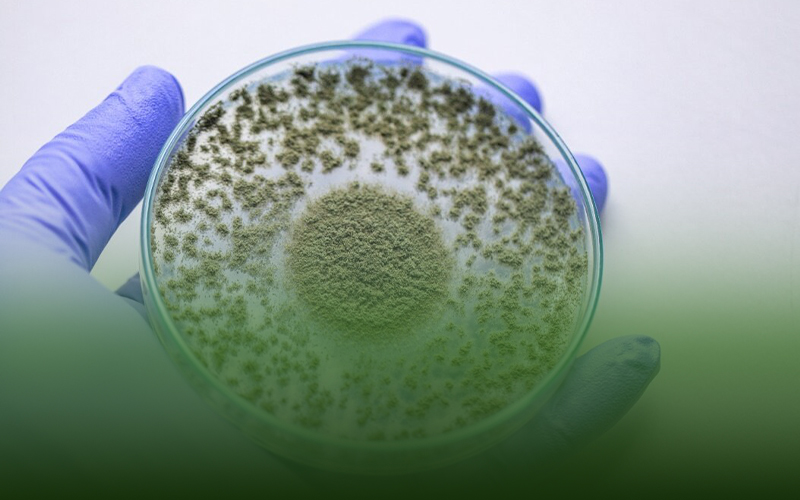

هیومیک اسید (Humic acid) یکی از مواد آلی می باشد که به طور طبیعی در زیر خاک پنهان شده است و و در کشاورزی مدرن به ابزاری محبوب و کاربردی برای کشاورزان و باغداران تبدیل شده است.
هیومیک اسید مایا رشد،برای بهبود سلامت خاک،افزایش در دسترس بودن مواد مغذی و افزایش رشد و عملکرد گیاه در کشاورزی مورد استفاده قرار می گیرد.
کود هیومیک اسید یک کود کاملا ارگانیک و طبیعی است و به دلیل همین ویژگی می تواند برای تمام محصولات کشاورزی استفاده شود.کود هیومیک اسید برای بهبود خاک، افزایش عملکرد گیاهان،افزایش جذب عناصر مغذی توسط گیاهان، کاهش استرس زیستی و حمایت از سیستم ریشه مناسب،استفاده می شود.
جهت مطالعه بیشتر در خصوص شرایط و طریقه مصرف هیومیک اسید به مقاله:شرایط و نحوه (طریقه) مصرف کود هیومیک اسید (Humic acid)مایا رشد مراجعه فرمایید.
شرکت مایا رشد،تولید کننده انواع کود تحت لیسانس MayaHofHeiomآلمان،قصد دارد در این مقاله شما را با ،هیومیک اسید(Humic acid) چیست و کودهیومیک اسید مایا رشد چه کاربردی هایی دارد؟ آشنا سازد.
مفاهیمی که در این مقاله به آنها پرداختیم، عبارتند از:
همه چیز درباره هیومیک اسید
کاربرد کود هیومیک اسید در کشاورزی
اشکال مختلف کود هیومیک اسید
نحوه استفاده از کود هیومیک اسید مایا رشد در کشاورزی
اهمیت و فواید کود هیومیک اسید مایا رشد در کشاورزی
نتیجه گیری

همه چیز درباره هیومیک اسید
اسید هیومیک یک ماده آلی طبیعی است که از تجزیه بیولوژیکی و شیمیایی مواد گیاهی و حیوانی به دست می آید.این ترکیب پیچیده ای از اسیدهای آلی، هومین ها و اسیدهای فولویک است که در خاک و ذغال سنگ یافت می شود.اسید هیومیک محلول در آب است و رنگ آن قهوه ای تیره تا سیاه است.
اسید هیومیک قرن ها به دلیل خواص دارویی آن مورد استفاده قرار گرفته است و در سال های اخیر به دلیل فواید بی شماری که برای رشد گیاهان و سلامت خاک دارد، در صنعت کشاورزی نیز مورد توجه قرار گرفته است.

کاربرد کود هیومیک اسید در کشاورزی
کود هیومیک اسید در کشاورزی مدرن کاربرد های زیادی دارد.همچنین از این کود برای مصارف خانگی،گیاهان آپارتمانی و انواع درختان استفاده می شود.اسید هیومیک یک عامل کلات کننده طبیعی است،به این معنی که می تواند به یون های مواد مغذی مانند آهن، کلسیم و منیزیم متصل شود و آن ها را در خاک نگه می دارد.
اسید هیومیک یک نرم کننده آلی خاک است و مشخص شده است که ساختار خاک را بهبود می بخشد، دسترسی به مواد مغذی را افزایش می دهد و در رشد و عملکرد گیاه نقش دارد. این کار با افزایش ظرفیت تبادل کاتیونی (CEC) خاک کار میکند که به آن اجازه میدهد تا مواد مغذی را به طور موثرتری حفظ کرده و آزاد کند.این بدان معنی است که گیاهان دسترسی بهتری به مواد مغذی مورد نیاز برای رشد و شکوفایی دارند.
اسید هیومیک همچنین به بهبود خواص فیزیکی خاک مانند حفظ آب و هوادهی کمک می کند.این می تواند به کاهش فشردگی خاک کمک کند،که می تواند رشد ریشه و جذب مواد مغذی را بهبود بخشد.
علاوه بر این،اسید هیومیک برای تحریک رشد میکروارگانیسم های مفید در خاک،که می تواند به سرکوب پاتوژن های مضر و بهبود سلامت کلی خاک کمک کند، مورد استفاده قرار می گیرد.
در نتیجه، اسید هیومیک یک ابزار ارزشمند برای کشاورزان و باغدارانی است که به دنبال بهبود سلامت خاک،افزایش در دسترس بودن مواد مغذی و افزایش رشد و عملکرد گیاه هستند.مزایای بی شمار کود هیومیک اسید مایا رشد، آن را به ابزاری همه کاره و مؤثر برای کشاورزی پایدار تبدیل می کند.
کود هیومیک اسید شامل موادی همچون اسید هیومیک، اسید فولوویک و اسید آمینه است که باعث افزایش عملکرد و کیفیت محصولات کشاورزی میشود.برخی از کاربردهای کود هیومیک اسید در کشاورزی عبارتند از:
1. افزایش جذب آب و عناصر غذایی: کود هیومیک اسید با افزایش خاصیت نفوذپذیری خاک و کاهش پتانسیل خمیری و همچنین با افزایش ظرفیت نگهداری رطوبت در خاک، میتواند باعث افزایش جذب آب و عناصرغذایی توسط گیاه شود.
2. افزایش کیفیت محصول:کود هیومیک اسید مایا رشد با افزایش سطح کلروفیل و تولید کروموزوم دار و بهبود کیفیت خوشهها، میتواند باعث بالا رفتن کیفیت محصول شود.
3. بهبود سازگاری محیطی:کود هیومیک اسید میتواند با افزایش عملکرد سیستم ایمنی گیاه بهترین سازگاری را با شرایط مختلف محیطی فراهم کند.
4. بهبود ساختار خاک:اسید هیومیک در خاک،باعث افزایش مقاومت بیشتر خاک در مقابل باد و آب می شود.
5. سازگاری با محیط زیست:با استفاده از کود هیومیک اسید به عنوان یک منبع طبیعی و ارگانیک، میتوان با حفظ محیط زیست و کاهش استفاده از کودهای شیمیایی، به حفظ تعادل زیست محیطی کمک کرد.
به طور کلی، کود هیومیک اسید به عنوان یک کود ارگانیک با مزایای بسیاری در کشاورزی استفاده میشود و میتواند باعث بهبود کیفیت و عملکرد محصولات کشاورزی شود.
جهت کسب اطلاعات بیشتر در خصوص کاربرد های کود هیومیک اسید به مقاله”کاربرد و مزایای مصرف کود Humic acid مایا رشد“مراجعه فرمایید.
اشکال مختلف کود هیومیک اسید
کود هیومیک اسید دارای اشکال مختلفی مانند گرانول،مایع،پودری و پرک می باشد،که هر یک ویژگی های مخصوص به خود را دارد.به طور کلی هیومیک اسید به دو نوع فعال و غیر فعال تقسیم بندی می شود.اسیدهیومیک فعال به صورت مایع و پودر می باشد و در آب قابلیت حلالیت دارد اما نوع غیر فعال به صورت گرانول است و در آب حل نمی شود.
کشاورزان میتوانند با انتخاب روش مناسب کوددهی و آگاهی از ویژگیهای کود هیومیک اسید در اشکال مختلف،به بهبود تغذیه خاک و محصولات خود کمک کنند. به دلیل وجود ناخالصیهایی در نوع مایع،توصیه میشود از کود هیومیک اسید به صورت پرک استفاده شود.
یکی از مزایای مهم هیومیک اسید پرک،آهستهرهش بودن آن است که به تدریج در آب حل میشود و از تهنشین شدن دانههای هیومیک اسید در مخزن جلوگیری میکند،این ویژگی منجر به حل کامل آن میشود. هیومیک اسید پرک مایا رشد دارای خلوص 70 درصد و 16 درصد پتاسیم بوده و به طور کامل در آب حل میشود.
به طور کلی، میزان حلشدگی هیومیک اسید در اشکال پرک، پودری و مایع به عواملی مانند اندازه ذرات،ترکیب شیمیایی و شرایط محیطی وابسته است.هر شکل از این کود خواص و کاربردهای ویژهای دارد و انتخاب نوع مناسب به نیاز و شرایط کشاورز بستگی دارد.
برای کسب اطلاعات بیشتر درباره انواع کود هیومیک اسید می توانید یه مقاله انواع کود هیومیک اسید مایا رشد و موارد مصرف آنها مراجعه فرمایید.

نحوه استفاده از کود هیومیک اسید مایا رشد در کشاورزی
نحوه استفاده از کود هیومیک اسید در تمامی فرم های خود از جمله مایع و پودری به صورت مصرف خاکی می باشند.که رایج ترین روش استفاده از کود هیومیک اسید روش کود آبیاری است.
همچنین در رابطه با دیگر روش های مصرف باید اشاره کرد که روش محلول پاشی روی شاخ و برگ گیاهان برای کود هیومیک اسید، به دلیل بزرگتر بودن ذرات آن نسبت به منافذ برگ امکان پذیر نمی باشد.به همین دلیل روش کود آبیاری برای استفاده از هیومیک اسید پیشنهاد می شود.
در روش کود آبیاری کود مورد نظر داخل آب حل شده وبه پای گیاه ریخته می شودو متناسب با سیستم آبیاری مزرعه و زمین کشاورزی شرایط استفاده می تواند متفاوت باشد.همچنین دوز مصرفی کود هیومیک اسید به نوع محصولات زراعی و درختان میوه بستگی دارد.
جهت کسب اطلاعات بیشتر در این خصوص به مقاله”میزان و زمان مصرف کود هیومیک اسید/هیومات پتاسیم مایا رشد برای گیاهان آپارتمانی و خانگی“مراجعه شود.
دوز پیشنهادی کود هیومیک اسید مایا رشد
| کود هیومیک اسید برای محصولات زراعی | 3 کیلو گرم در 1 هکتار |
| کود هیومیک اسید برای درختان | 3 تا تا 5 کیلو گرم در 1 هکتار |
اگه تا بحال از کود هیومیک اسید در خاک استفاده نشده و آنالیز خاک نشان دهنده پی اچ بالا یا شوری خاک باشد استفاده بیشتر از کود هیومیک اسید امکان پذیر می باشد.
کود هیومیک اسید 70 درصد مایا رشد با 16 درصد پتاسیم نقش مهمی در افزایش و بهبود توانایی گیاهان دارد و باعث افزایش توانایی جذب مواد مغذی از خاک توسط گیاهان می شود.

کود هیومیک اسید 70 درصد مایا رشد
اهمیت و فواید کود هیومیک اسید مایا رشد در کشاورزی
استفاده از کود هیومیک اسید در کشاورزی مزایای بی شماری دارد که از آن جمله می توان به موارد زیر اشاره کرد:
1. بهبود سلامت خاک:
کود هیومیک اسید مایا رشد می تواند ساختار خاک را بهبود بخشد، نگهداری آب و فعالیت میکروبی خاک را افزایش دهد.این می تواند به احیای خاک های تخریب شده و بهبود سلامت کلی خاک کمک کند، که می تواند باعث رشد سالم گیاه شود.
2. افزایش در دسترس بودن مواد مغذی:
کود هیومیک اسید مایا رشد می تواند ظرفیت تبادل کاتیونی (CEC) خاک را افزایش دهد که به آن اجازه می دهد تا مواد مغذی را به طور موثرتری حفظ کند و آزاد کند.این بدان معنی است که گیاهان دسترسی بهتری به مواد مغذی مورد نیاز برای رشد و شکوفایی دارند.
3. افزایش رشد و عملکرد گیاه:
کود اسید هیومیک مایا رشد می تواند رشد ریشه را تحریک کند،رشد گیاه سالم را تقویت کند و عملکرد محصول را افزایش دهد.همچنین می تواند تحمل گیاه را در برابر عوامل استرس زای محیطی،مانند خشکی یا دمای شدید، که می تواند انعطاف پذیری محصول را بهبود بخشد، بهبود بخشد.
4. حمایت از کشاورزی پایدار:
کود هیومیک اسید مایا رشد یک منبع طبیعی و پایدار از مواد مغذی گیاهی است.این می تواند در هر دو سیستم کشاورزی ارگانیک و معمولی استفاده شود و با اکثر کودها و آفت کش ها سازگار است.
5. کاهش اثرات زیست محیطی:
کود هیومیک اسید مایا رشد می تواند به کاهش شستشوی مواد مغذی و مواد شیمیایی به محیط کمک کند، که می تواند اثرات منفی کشاورزی بر کیفیت آب و محیط زیست را کاهش دهد.
به طور خلاصه،استفاده از کود هیومیک اسید در کشاورزی می تواند مزایای متعددی از جمله بهبود سلامت خاک، افزایش در دسترس بودن مواد مغذی، افزایش رشد و عملکرد گیاه، ترویج شیوه های کشاورزی پایدار و کاهش اثرات زیست محیطی را به همراه داشته باشد.استفاده از کود هیومیک اسید مایا رشد نقش مهمی را در کشاورزی پایدار ایفا می کند.
شما می تواید برای مطالعه بیشتر به مقاله”مزایا و معایب استفاده از انواع کود اسید هیومیک پودر، مایع و گرانول مایا رشد“مراجعه کنید.

چرا هیومیک اسید به صرفه ترین روش برای اصلاح خاک می باشد؟
هیومیک اسید به دلیل خواص منحصر به فردش یکی از بهترین گزینهها برای اصلاح خاک و بهبود رشد گیاهان محسوب میشود. دلایل اصلی استفاده از این کود عبارتند از:
افزایش رشد و جوانهزنی: هیومیک اسید سرعت رشد گیاه و جوانهزنی بذرها را افزایش میدهد و بهترین زمان استفاده از آن، هنگام کاشت است.
بهبود جذب مواد مغذی: این کود با پیوند به مواد مغذی موجود در خاک،آنها را برای گیاهان در دسترستر میکند و جذب عناصر حیاتی را افزایش میدهد.
تقویت فعالیت میکروبی: هیومیک اسید رشد میکروارگانیسمهای مفید خاک را تقویت میکند و به تجزیه مواد آلی و آزادسازی مواد مغذی کمک مینماید.
دوستدار محیط زیست: هیومیک اسید یک کود طبیعی است که وابستگی به کودهای شیمیایی را کاهش میدهد و برای محیط زیست ایمنتر است.
افزایش مقاومت به استرس:این کود مقاومت گیاهان را در برابر شرایط سخت مانند خشکی، سرما و بیماریها تقویت میکند.
کاهش شوری خاک: هیومیک اسید به کاهش شوری خاکهای شور کمک میکند و شرایط مناسبتری برای رشد گیاهان فراهم میآورد.
نتیجه گیری
به طور کلی، استفاده از اسید هیومیک در کشاورزی می تواند مزایای متعددی از جمله بهبود سلامت خاک، افزایش در دسترس بودن مواد مغذی، افزایش رشد و عملکرد گیاه، ترویج شیوه های کشاورزی پایدار و کاهش اثرات زیست محیطی را به همراه داشته باشد.
منشاء طبیعی آن را به گزینه ای پایدار و سازگار با محیط زیست برای کشاورزی تبدیل می کند، و احتمالاً نقش مهمی را در کشاورزی پایدار ایفا می کند زیرا ما به دنبال تغذیه جمعیت رو به رشد جهانی و در عین حال حفظ منابع طبیعی خود هستیم.
خرید کود کلات آهن مایا رشد
یکی دیگر از کاربردی ترین و پر مصرف ترین کود های کشاورزی کود کلات آهن می باشد.کود کلات آهن نوعی کود حاوی آهن به شکلی است که به راحتی توسط گیاهان جذب می شود.آهن یک ریزمغذی ضروری برای رشد و نمو گیاهان است و کمبود آن می تواند منجر به توقف رشد، زرد شدن برگ ها و کاهش عملکرد محصول شود.کود کلات آهن می تواند به جلوگیری از این کمبودها و رشد سالم گیاه کمک کند.
کود کلات آهن مایا رشد (Iron chelated fertilizer) برای تقویت رشد گیاهان استفاده میشود و دارای پایداری تضمین شده درpH های 3 تا 11،قابلیت جذب سریع، بهبود کیفیت محصولات،تقویت رشد و افزایش عملکرد گیاه می باشد.
کود کلات آهن مایا رشد با فرمولاسیون اختصاصی، پایداری و عملکرد بهتری نسبت به سایر کلات های آهن در بازار دارد.
کود کلات آهن مایا رشد را می توان در روش های مختلف کوددهی از جمله کود آبیاری ،چالکود و محلول پاش استفاده کرد که انعطاف پذیری را برای کشاورزان فراهم می کند تا بهترین روش را برای شرایط محیطی خاص خود انتخاب کنند.
شما می توانید جهت خرید کود کلات آهن، به فروشگاه مایا رشد مراجعه فرمایید.

سوالات رایج درباره استفاده از کود هیومیک اسید
مهمترین ویژگی کود هیومیک اسید اصلاح خاک می باشد،که همین امر منجر به بهبود رشد ریشه گیاه و افزایش جذب عناصر غذایی و در نهایت به افزایش کیفیت محصول می شود.
مناسب ترین روش استفاده از کود هیومیک اسید روش کود آبیاری می باشد.
کود هیومیک اسید برای همه ی گیاهان از جمله زراعی،درختان میوه،گیاهان زینتی و آپارتمانی قابل استفاده می باشد و محدودیت مصرفی وجود ندارد.
کود هیومیک اسید را می توان در تمام شرایط خاک از جمله گرم،خشک، معتدل و … استفاده کرد.
کود هیومیک اسید قابلیت اصلاح خاک از نظر شوری و ph بالای را به تدریج دارد.
این فرایند می تواند زمان بر باشد ولی با چند بار استفاده و به تدریج قطعا نتیجه مورد نظر حاصل می شود.
جهت کسب اطلاعات برای انتخاب و خرید کود هیومیک اسید می توانید به مقاله”راهنمای انتخاب و خرید بهترین هیومیک اسید/فولویک اسید مایا رشد مناسب هر گیاه/ لیست قیمت و خرید“مراجعه فرمایید.
برای مشاهده منبع خارجی استفاده شده در این مقاله به لینک زیر مراجعه فرمایید.
?What Is Humic Acid? Where Does It Come From
دانلود فایل PDF مقاله :

به عنوان یک کشاورز واقعا مطالب بسیار مفیدی بود که باید مطاله میکردم.
ممنون از توضیحاتتون.
یه سوال داشتم، تاثیر این کود در رشد گیاه چه قدر هست؟
ممنون
مهمترین تاثیر هیومیک اسید اصلاح ساختار خاک است که منجر به بهبود رشد ریشه شده و امکان جذب عناصر غذایی را افزایش میدهد و از این طریق باعث افزایش کمیت و کیفیت محصول میشود.
برای کسب اطلاعات بیشتر به مقاله چرا کود هیومیک اسید مایا رشد برای تقویت رشد گیاهان معجزه می کند؟ مراجعه فرمایید.
سلام وقت بخیر
باتشکر از مقاله ی خوب و مفید شما
میخواستم بپرسم آیا هیومیک اسید برای تمامی گیاهان قابل استفاده است ؟
سلام وقت بخیر
کود هیومیک اسید برای تمام گیاهان هم زراعی هم درختان و حتی گیاهان آپارتمانی قابل استفاده است.
فقط لازم است دوز توصیه شده رعایت شود.
برای کسب اطلاعات بیشتر می توانید به مقاله کود هیومیک اسید مایا رشد برای چه گیاهانی مناسب و برای چه گیاهانی مضر می باشد؟مراجعه فرمایید.